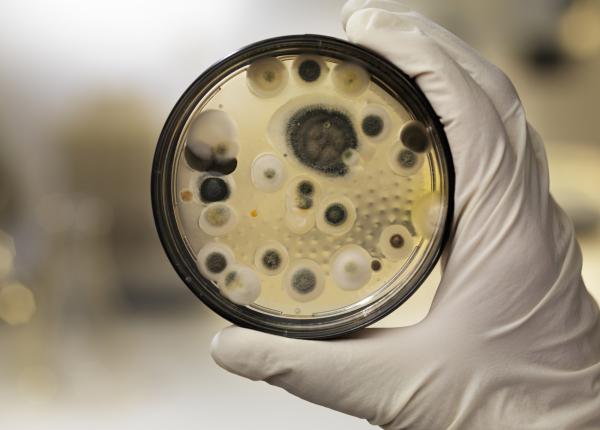
cercetatorii au transformat o ciuperca asociata mult timp cu moartea intr o potentiala arma impotriva cancerului

Tratamentele inovatoare pot salva vieţile a zeci de mii de pacienţi, însă România rămâne printre țările cu cel mai lent acces la ele
30 oct 2025
Tratamentele inovatoare pot salva vieţile a zeci de mii de pacienţi din ţara noastră. Din păcate, România rămâne printre țările cu cel mai lent acces la medicamente inovatoare din Uniunea...